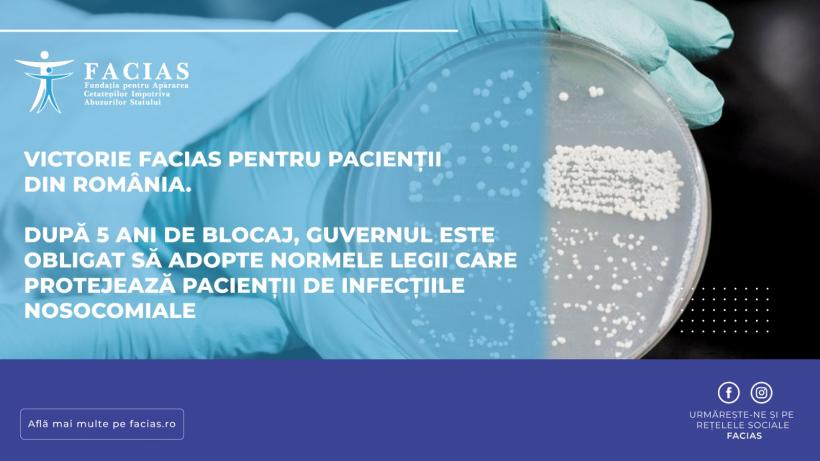
Victorie FACIAS pentru pacienții din România. După 5 ani de blocaj, Guvernul este obligat să adopte normele legii care protejează pacienții de infecțiile nosocomiale

Infecțiile nosocomiale reprezintă una dintre cele mai extinse și critice probleme nedeclarate din sistemul sanitar românesc. După ce normele vor fi adoptate, spitalele din țară, atât cele publice cât și cele private, vor fi obligate să raporteze transparent numărul real de infecții nosocomiale, să trateze pacienții care le-au contractat în timpul internării și să respecte un cadru legal clar de prevenire și intervenție. Normele vor include sancțiuni pentru unitățile medicale care omit sau falsifică raportările, sancțiuni care pot merge de la amenzi contravenționale până la retragerea avizului sanitar de funcționare, în funcție de gravitatea situației. Victoria obținută de FACIAS în instanță restabilește dreptul fundamental al cetățenilor de a fi protejați și informați corect cu privire la riscurile din unitățile medicale.
Legea nr. 3/2021, care reglementează supravegherea, prevenirea și controlul infecțiilor asociate asistenței medicale, a intrat în vigoare în ianuarie 2021. Cu toate acestea, prevederile sale esențiale au rămas fără efect juridic din cauza neîndeplinirii obligației Guvernului de a adopta normele metodologice. În lipsa acestor norme, spitalele au continuat să raporteze incomplet sau incorect cazurile de infecții dobândite de pacienți pe perioada internării.
FACIAS amintește că, deși în România se raportează oficial sub 1% infecții nosocomiale, față de o medie europeană care depășește 7%, realitatea din spitale contrazice dramatic aceste cifre. Dovada acestui eșec de raportare este reflectată în cazuri grave, care au ieșit la iveală în presă, precum cel din septembrie 2024, când 11 nou-născuți au fost infectați cu bacterii rezistente la Maternitatea Giulești din București, sau cel din august 2025, de la Spitalul Clinic de Urgență București (Floreasca), unde au fost confirmate trei infecții cu Candida auris, o ciupercă extrem de rezistentă și periculoasă.
FACIAS solicită Guvernului României să adopte urgent normele prevăzute de Legea nr. 3/2021 și să le publice în Monitorul Oficial. Legea anti-infecțiilor nosocomiale va permite pacienților să afle inclusiv care sunt spitale care înregistrează cele mai multe infecții.